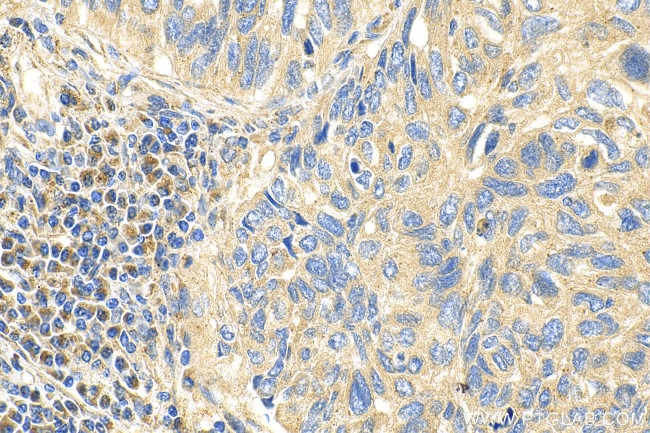
PCDHGC5 Antibody in Immunohistochemistry (Paraffin) (IHC (P))

Search
Proteintech
PCDHGC5 Polyclonal Antibody
{{$productOrderCtrl.translations['antibody.pdp.commerceCard.promotion.promotions']}}
{{$productOrderCtrl.translations['antibody.pdp.commerceCard.promotion.viewpromo']}}
{{$productOrderCtrl.translations['antibody.pdp.commerceCard.promotion.promocode']}}: {{promo.promoCode}} {{promo.promoTitle}} {{promo.promoDescription}}. {{$productOrderCtrl.translations['antibody.pdp.commerceCard.promotion.learnmore']}}
产品信息
23848-1-AP
种属反应
宿主/亚型
分类
类型
抗原
偶联物
形式
浓度
规格
纯化类型
保存液
内含物
保存条件
运输条件
产品详细信息
Sequence of this protein is as follows: LRYSVVEESE PGTLVGNVAQ DLGLKMTDLL SRRLQLGSEE NGRYFSLSLM SGALAVNQKI DRESLCGAST SCLLPVQVVT EHPLELIRVE VEILDLNDNS PSFATPEREM RISESAASGA RFPLDSAQDP DVGTNTVSFY TLSPNSHFSL NVKTLKDGKP FPELVLEQQL DREAQARHQL VLTAVDGGTP ARSGTTLISV IVLDINDNAP TFQSSVLRVG IPENAPIGTL LLRLNATDPD EGTNGQLDYS FGDHTSEAVR NLFGLDPSSG AIHVLGPIDF EESRFYEIHA RARDQGQPAM EGHCVIQVDV GDVNDNAPEV LLASLANPVL ESTPVGTVVG LFNVRDRDSG RNGEVSLDIS PDLPFQIKPS E
靶标信息
This gene is a member of the protocadherin gamma gene cluster, one of three related clusters tandemly linked on chromosome five. These gene clusters have an immunoglobulin-like organization, suggesting that a novel mechanism may be involved in their regulation and expression. The gamma gene cluster includes 22 genes divided into 3 subfamilies. Subfamily A contains 12 genes, subfamily B contains 7 genes and 2 pseudogenes, and the more distantly related subfamily C contains 3 genes. The tandem array of 22 large, variable region exons are followed by a constant region, containing 3 exons shared by all genes in the cluster. Each variable region exon encodes the extracellular region, which includes 6 cadherin ectodomains and a transmembrane region. The constant region exons encode the common cytoplasmic region. These neural cadherin-like cell adhesion proteins most likely play a critical role in the establishment and function of specific cell-cell connections in the brain. Alternative splicing has been described for the gamma cluster genes.
仅用于科研。不用于诊断过程。未经明确授权不得转售。
篇参考文献 (0)
生物信息学
蛋白别名: PCDH-gamma-C5; Protocadherin gamma-C5
基因别名: PCDH-GAMMA-C5; PCDHGC5
UniProt ID: (Human) Q9Y5F6
Entrez Gene ID: (Human) 56097